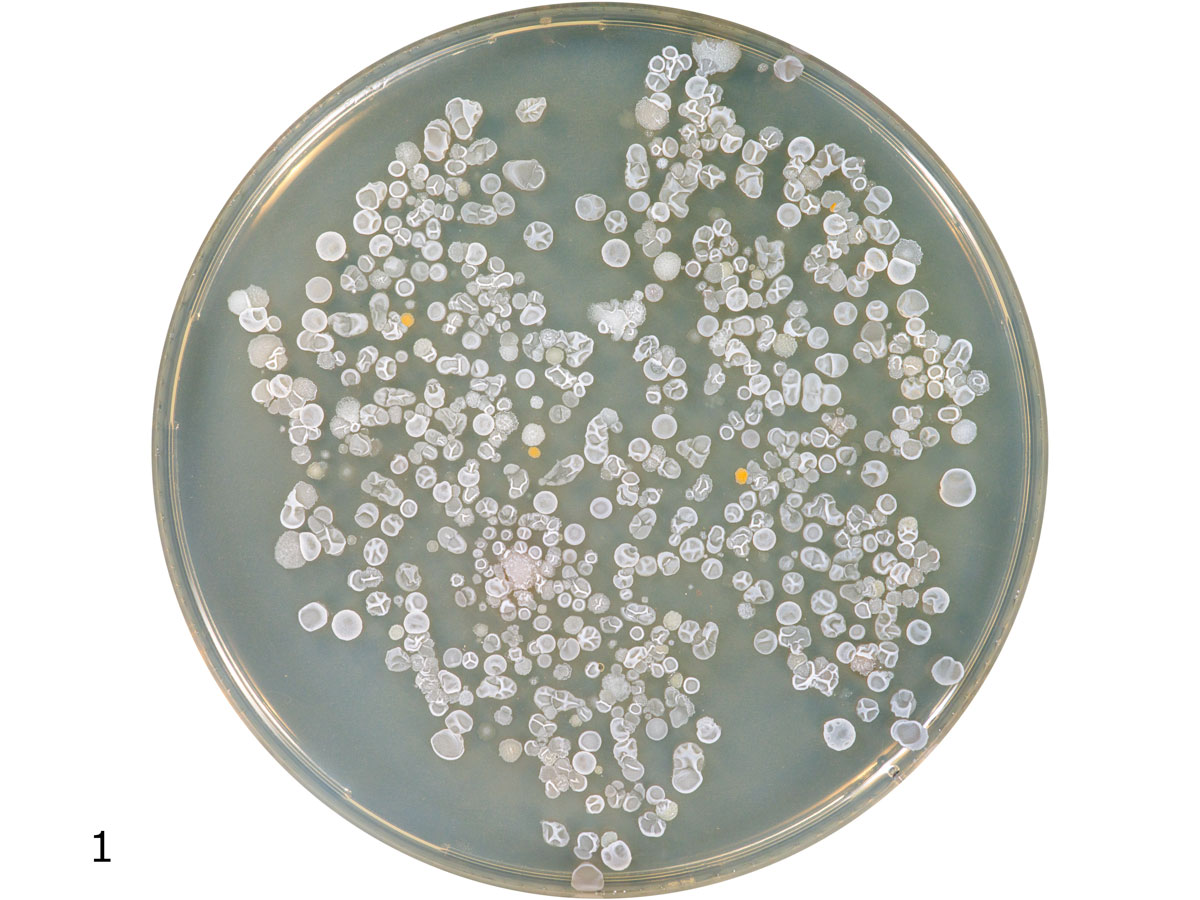
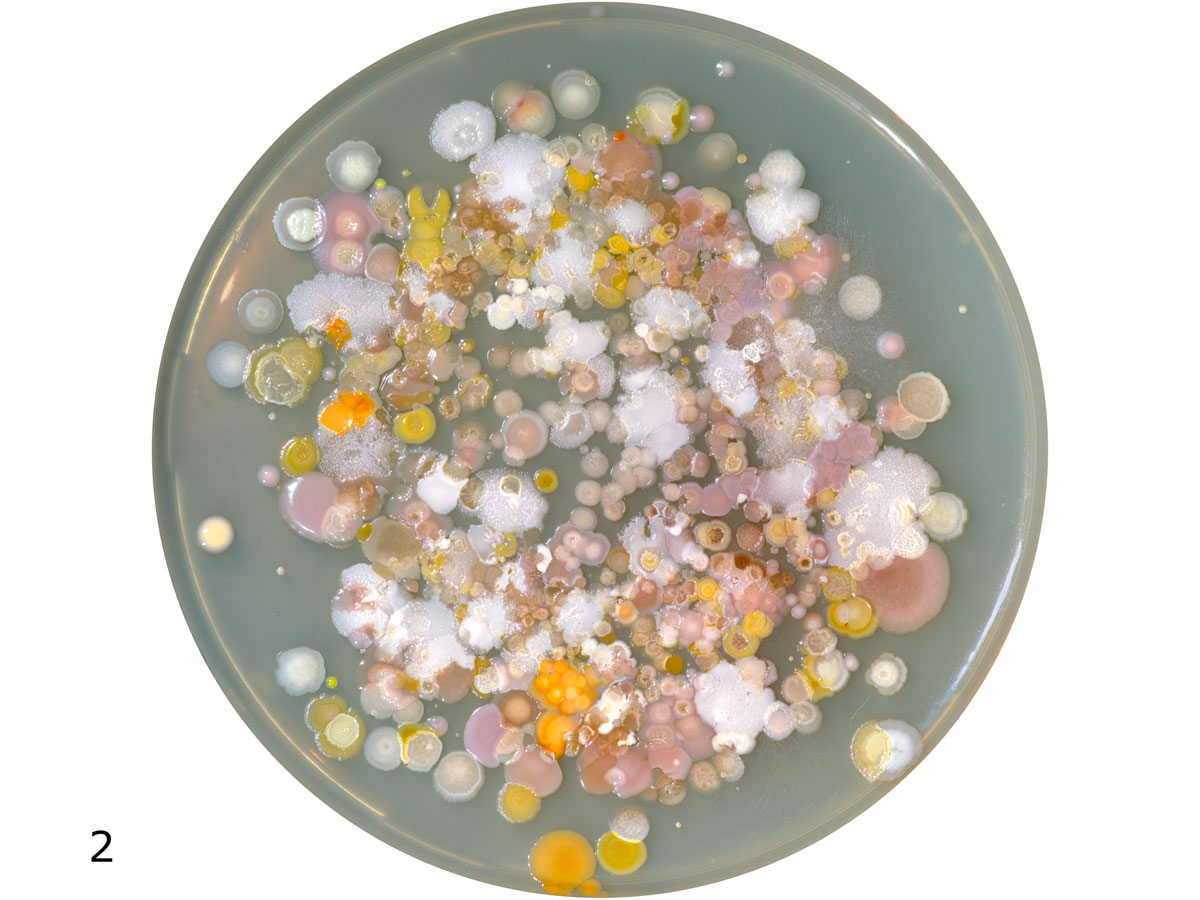
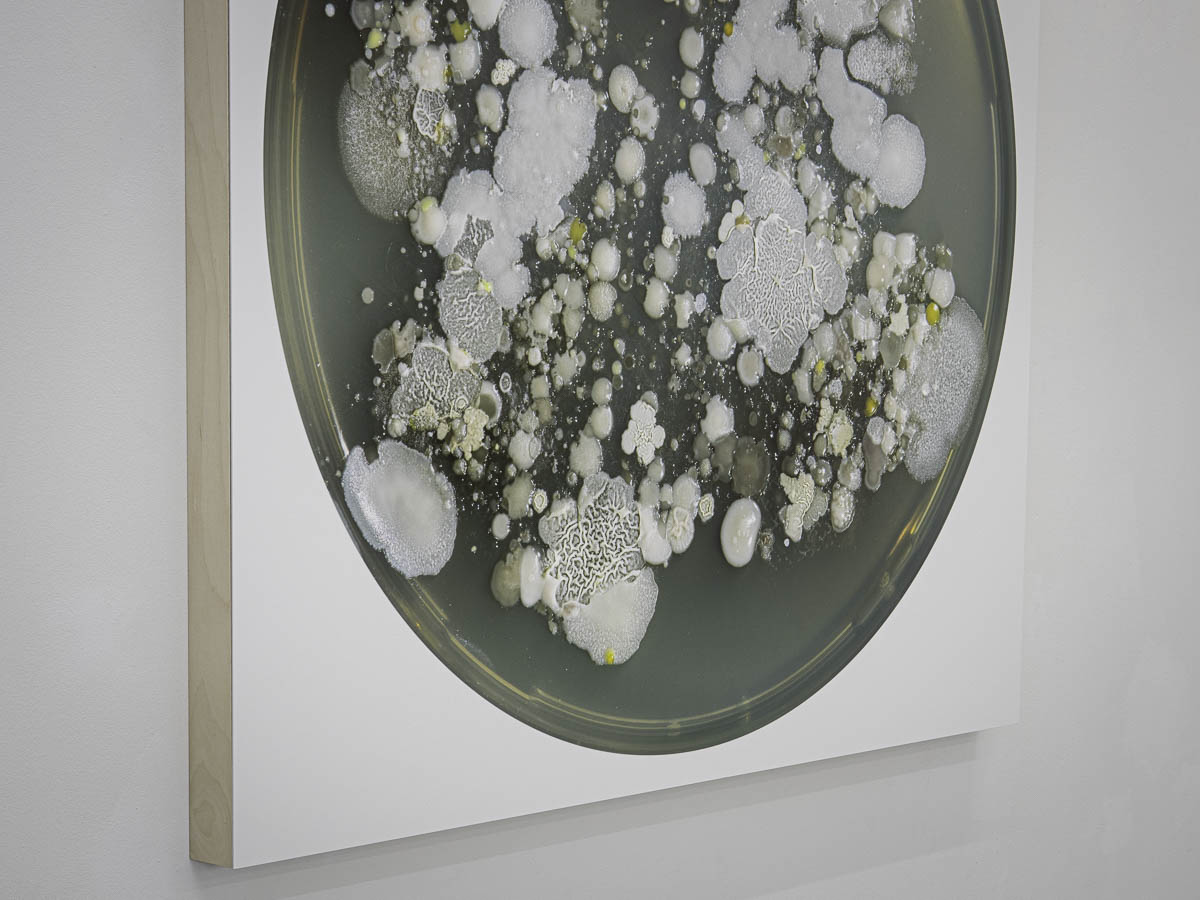
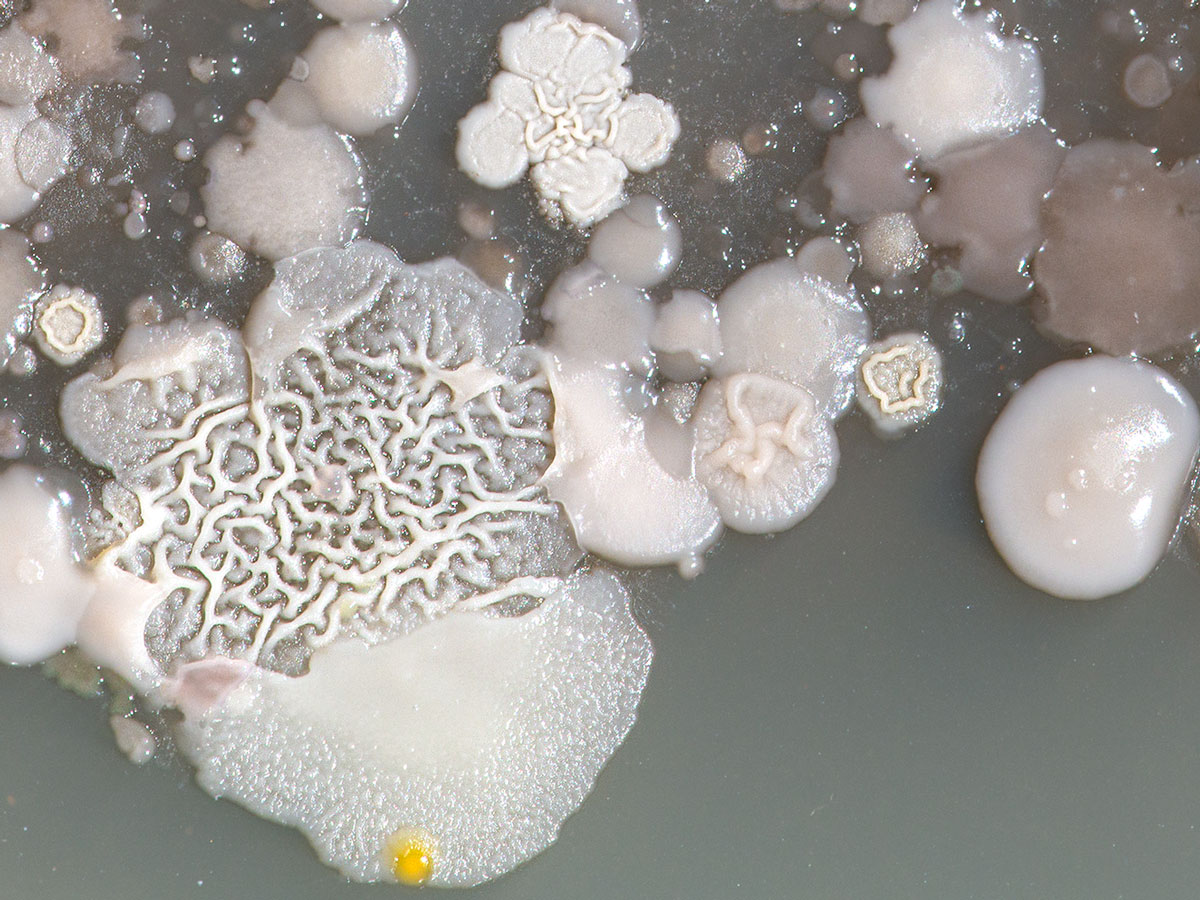
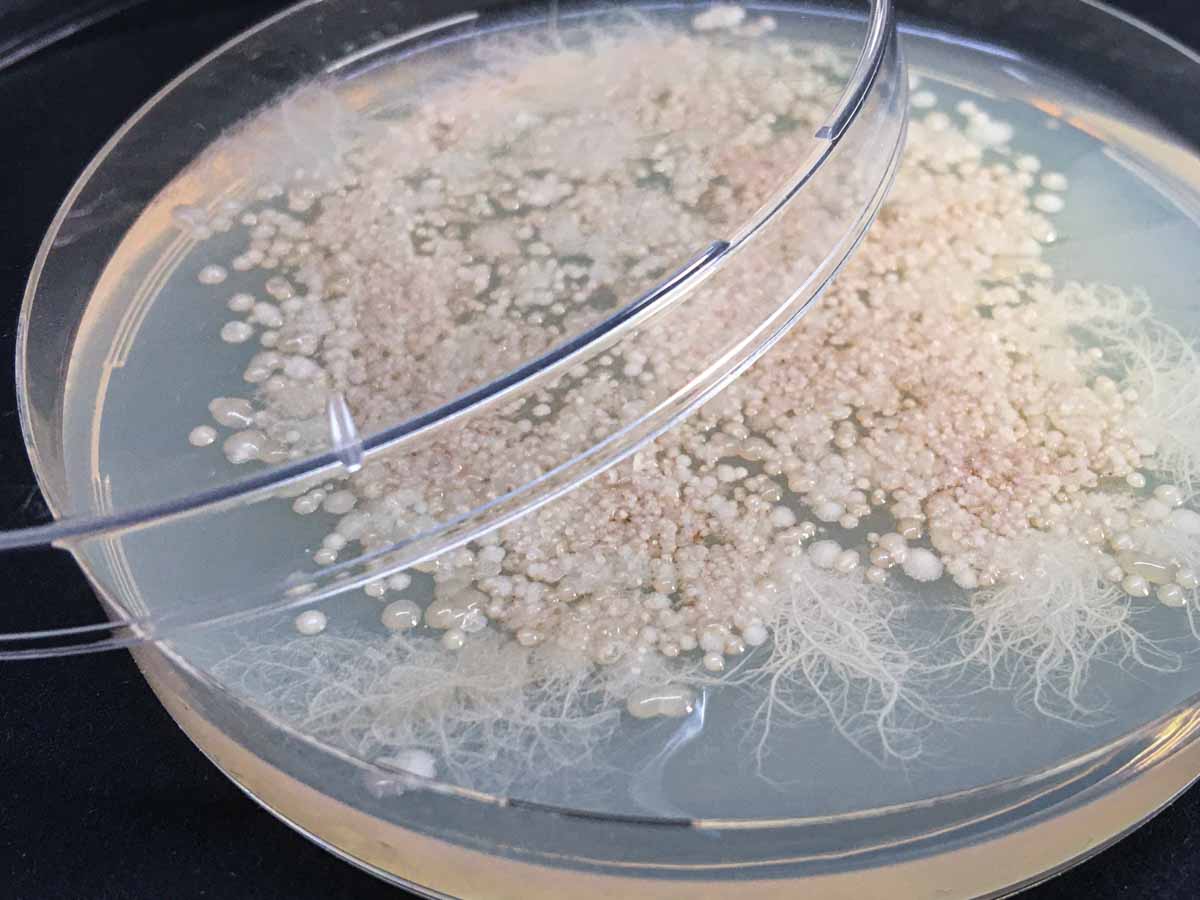

Terraforming (Soil Microbiota), 2018, en cours
Encre pigmentaire sur papier Canson Baryta, monté sur alu, 106 x 106 cm1 Saumure entre les pierres de la Spiral Jetty au Nord de Salt Lake City.
2 Huanan Market, Wuhan 武汉华南市场 | Marché aux animaux vivants désafecté à Wuhan.
3 Pointe de la Jonction, Genève | Sous-sol industriel pollué aux hydrocarbures, prélèvement à -3 mètres.
Le processus consiste à prélever dans un lieu donné un peu de terre ou de poussière, d'en extraire les microorganismes qui y vivent ou attendent en dormance (le microbiote du sol), et de les cultiver dans une boîte de Pétri sur un milieu gélosé adapté. La macrophotographie est prise après une période d'incubation allant de 48h à une semaine. L'échantillon de sol initial est par ailleurs conservé.